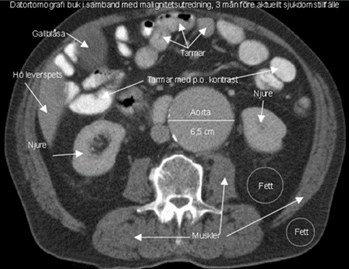

Vad ser du?

Hjärtat är allmänförstorat. Lungkärlen är vida och det finns ökad mängd pleuravätska bilateralt. Det finns spridda interstitiella och basalt på höger sida även alveolära infiltrat.
- Hjärtinkompensation.

Vad reagerar du på här?

Hjärtsviktmarkör
- NT-proBNP (restprodukt när proBNP klyvts till BNP)
- Frisätts vid ökad spänning i kammarvägg
- Minskar återupptag av Na+ i njure
- Se till höger för handläggning
- Förhöjda värden kan också tyda på att behandling inte är optimal
- Stort negativt prediktivt värde
- Högre vid ökad ålder

Vad visar bilderna?

Lungödem och normal lunga
Vad händer händer övergripande vid hjärtsvikt (SV, EDV, hormoner etc)?

Efter en hjärtinfarkt utvecklas först en kompensatorisk, excentrisk hypertrofi av myokardiet. En ogynnsam ombyggnad och bindvävsökning sker i den hypertrofierade muskulaturen. Detta kräver en ökad blodförsörjning, som kan försvåras av förändringar i koronarkärlen. Den initiala hypertrofin följs av en dilatation av de sjuka delarna. Resultatet blir ett ogynnsamt förhöjt fyllnadstryck på basen av såväl systolisk (bristande pumpfunktion) som diastolisk (försämrad tänjbarhet/fyllnad) dysfunktion.
Vad kan vara det som leder hjärtsvikt i progress utöver ovan?
Den utlösande faktorn till Johans hjärtsviktsymptom är ett nytillkommet förmaksflimmer, som minskar blodfyllnaden till kamrarna (kicken blir ännu viktigare vid hjärtsvikt).
En hög kammarfrekvens minskar ytterligare hjärtats effektivitet/hjärtminutvolym.
Hur ser mortalitet ut för obehandlad hjärtsvikt efter fem år?
50 %
Torrhosta är en relativt vanlig biverkan av ACE-hämmare. ACE finns både fritt i cirkulationen och lokalt, särskilt i lungorna.
Vad är mekanismen bakom detta och vad kan man byta till?
ACE-hämmare minskar nedbrytningen av bradykinin och substans P, vilket leder till en neurogen inflammation i luftrören. Man byter till en AT1-receptor blockerare, som blockerar en nivå lägre i RAAS och därför inte påverkar bradykinin.
Johan inkommer med symptom och fysikaliska tecken på uttalad hjärtsvikt i form av läppcyanos, halsvenstas, ansträngningsdyspné, lungrassel, dämpning basalt över lungfälten, hepatomegali, dekliva pittingödem och sekundär mitralisinsufficiens. Inkompensationsbilden bekräftas med lungröntgen. QS-komplex sågs anteroseptalt och inferiort, vilket talar för genomgångna infarkter.
Ekokardiografi visar en uttalad nedsättning av vänsterkammarfunktionen orsakad av tidigare infarkter. En del av hjärtmuskeln apikalt har efter myokardnekros ersatts med ett bindvävsärr och blivit akinetisk, vilket innebär att den inte deltar i hjärtmuskelkontraktionen. Diagnosen hjärtsvikt bygger på förekomst av symtom och objektivt påvisad nedsättning av hjärtfunktionen.
Efter en hjärtinfarkt utvecklas först en kompensatorisk, excentrisk hypertrofi av myokardiet. En ogynnsam ombyggnad och bindvävsökning sker i den hypertrofierade muskulaturen. Detta kräver en ökad blodförsörjning, som kan försvåras av förändringar i koronarkärlen. Den initiala hypertrofin följs av en dilatation av de sjuka delarna. Resultatet blir ett ogynnsamt förhöjt fyllnadstryck på basen av såväl systolisk (bristande pumpfunktion) som diastolisk (försämrad tänjbarhet/fyllnad) dysfunktion.
Den utlösande faktorn till Johans hjärtsviktsymptom är ett nytillkommet förmaksflimmer, som minskar blodfyllnaden till kamrarna. En hög kammarfrekvens minskar ytterligare hjärtats effektivitet/hjärtminutvolym.
Hur medicinerar du och vilken effekt får du?
De hormonella kompensationsmekanismerna är aktiverade och för att bryta denna onda cirkel inleds behandling med ACE-hämmare och betareceptorblockerare.
Detta ger minskat afterload och därmed en avlastning av hjärtat genom dilatation på fr.a. artärsidan.
På grund av förmaksflimmer och nedsatt vänsterkammarfunktion insätts apixaban (blockerar faktor Xa) för att minska risken för tromboembolism, kanske ASA
Även blodfettsänkande, statiner (hämmar acetyl-CoA-reduktas) eventuellt.
Vad ser du på denna bild?
- (Nedom njurartärnivå finns ett 10 cm långt) bukaortaneurysm med en vidd av drygt 6.5 cm.
Vad ser du på bilden?

- Bukaortaaneurysm med stort vänstersidigt hematom och pågående blödning retroperitonalt.
Vad ser du?

“Fiskmunn” vid mitralisstenos
Vad ser du?

Förmodad urinblåsetumör
Vad ser du?

Förmodad urinblåsetumör
Vad är detta?

Cancer i urinblåsa (urotel)
Vad visar röntgen?

Bild förenlig med t ex KOL
Gles kärlteckning, särskilt apikalt (emfysem ev) och antytt avplanade diafragmakupoler, särskilt höger, förenligt med KOL. Något förstorat hjärta men ingen stas.
Litet infiltrat basalt höger

Vad ser du här?

Uttalat emfysem inom bägge ovanlober. Basalt ventralt i höger lunga finns en liten tumörmisstänkt förändring.



